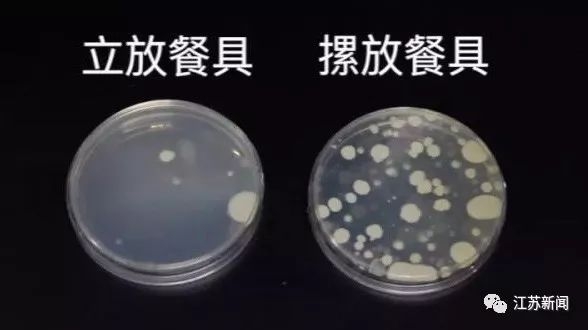

洗好的碗盘摞着放,等于在培养细菌?这个实验推翻你多年的习惯
江苏新闻
2019-10-17 14:43
洗碗之后
有人喜欢立着放
很多人则习惯直接摞在一起
网传摞着放会给餐具带来二次污染?
真的吗?
为验证实际情况
记者来到某微生物实验室
进行检测求证
碗碟分成两组
高温灭菌后用无菌肉汤进行涂抹
再进行冲洗
模拟平时洗碗的过程
洗净碗碟分为两组
一组放在碗碟架上晾干后放入碗橱柜
一组摞起放直接放入碗橱柜
3天后检测菌落总数
结果显示
检测结果证实了网传说法!
记者原本以为菌落总数相差不会太大
但没想到,两者相差最大高达
12倍以上!
专家解释
直接摞着放不利于空气流通
湿度较大
有利于微生物的生长
因此摞着放的碗碟菌落总数
要高于立着放的
餐具正确清洁步骤:
1、碗碟清洗后,用流动清水冲洗干净。
2、再立于镂空碗碟架上沥干。
3、等没有水滴后,放入橱柜。
4、其他餐具,如锅铲、筷子、砧板等,也建议立放。
提醒:洗碗布莫当“万能布”
洗完餐具尽量不要用抹布擦干,如果擦拭,可将抹布先在开水中煮烫,高温消毒后再使用。
你家碗盘洗完后,是怎么放的?
来源:江苏新闻(ID:jstvjsxw)
(编辑:叶映橙)
评论